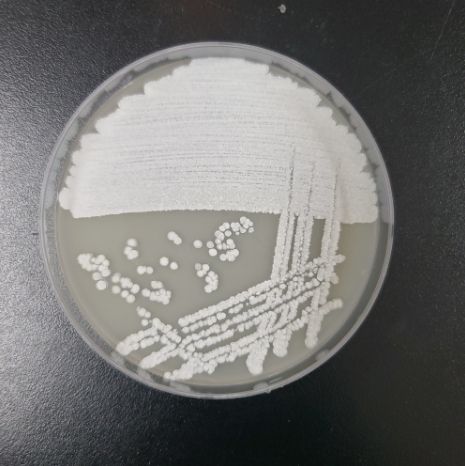

(비전21뉴스) 환경부 소속 국립생물자원관(관장 유호)은 자생 방선균(스트렙토마이세스 카나마이세티쿠스)에서 일반 항생제에 내성을 지닌 황색포도알균의 증식을 억제하는 항생물질을 최근 발견했다고 밝혔다.
황색포도알균의 감염 치료에는 페니실린계 항생제인 메티실린이 사용되어 왔는데, 1961년 영국에서 최초 발견된 ‘메티실린 내성 황색포도알균’은 메티실린 외에도 다양한 종류의 항생제에 내성을 보여 대표적인 ‘슈퍼박테리아’로 알려져 있다. 이에 따라 세계보건기구(WHO)에서도 내성 황색포도알균을 신규 항생제 개발이 시급한 병원균으로 지정하고 있다.
국립생물자원관은 2024년부터 고려대학교 및 건국대학교 연구진과 공동 연구를 수행해 자생 방선균의 유전자 데이터 분석을 통해 항생물질을 생산하는 유전자군을 찾아냈고, 해당 유전자군에서 내성균의 증식을 억제하는 효과가 있는 항생물질 ‘스베타마이신 C’가 생산되는 것을 확인했다. ‘스베타마이신 C’는 2017년 국제 학계에 보고된 후 국내에서는 처음 발견됐다.
이번 연구는 최근 항생제 원료의 해외 의존도가 높아 국산화의 필요성이 대두되고 있는 상황에서 자생 미생물에서 항생물질을 찾았다는 데 의미가 있다.
관련 연구 결과는 미생물학 국제 학술지(Journal of Microbiology) 2025년 9월호에 게재될 예정이다.
유호 국립생물자원관장은 “미생물에는 아직 우리가 모르는 수많은 유용한 유전정보가 숨겨져 있다”라며, “유용한 유전정보의 확보를 통해 고부가가치 물질 생산 연구를 지속 추진할 계획”이라고 밝혔다.






